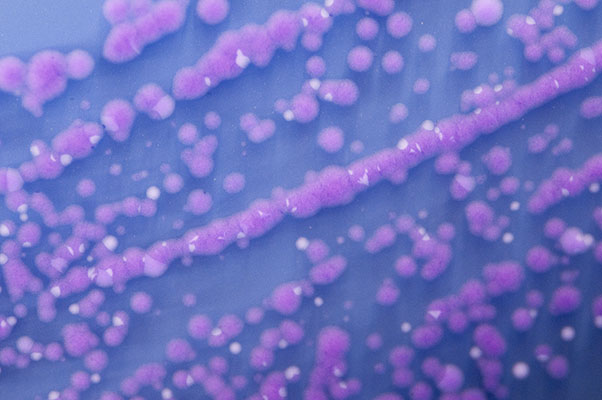
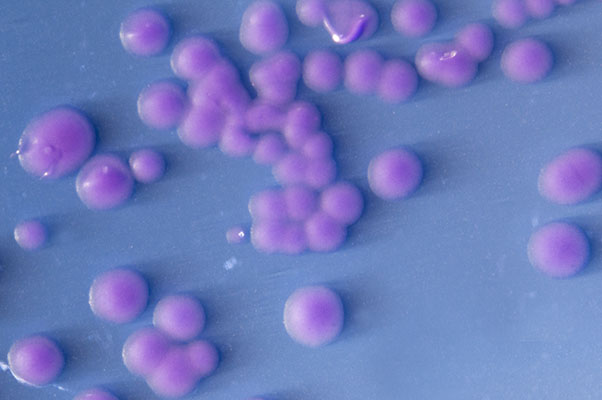
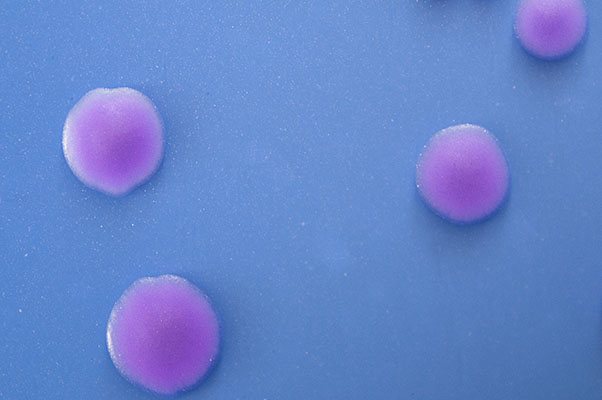

|
Kingdom: Bacteria Phylum: Firmicutes Class: Bacilli Order: Lactobacillales Family: Streptococcaceae Genus: Streptococcus Species: agalactiae |
Streptococcus agalactiae is a beta-hemolytic gram-positive bacteria. It is also known as “Group B streptococcus” (or GBS). They are normally found in the gastroinstesinal flora in humans and in the female urogenital tract and rectum. S. agalatiae can act in a variety of manners, depending on the condition of the body it is residing in. It is a diplococcal gram-positive, non acid-fast bacterium found in pairs or chains. It is inmotile, does not form spores, contains the group B Lancefield antigen, and catalase-free, where it does not catalyze the reduction of hydrogen peroxide.
S. agalactiae is very sensitive to bile and will lyse if it is in contact with it as a result. The detection of S. agalactiae can be achieved in various ways, such as a CAMP (Christie Atkins Munch-Petersen) test, can be performed; however if its presence is need of controlling, i.e. infection, it can be very difficult due to the fact that it is naturally occuring in the human body. S. agalactiae is capable of serious infections, such as group B streptococcal infections in infants (neonatal septicemia and meningitis), where the bacteria can be transferred to the infant during birth via the birth canal of the woman. Group B streptococcal infections can also be found in older people or those individuals with comprised immune systems. It is also considered an infectious pathogen when such colonies are found in the blood, uterus, brain and the meninges. S. agalactiae’s “virulence factor” can be attributed to its polysaccharide antiphagocytic capsule produced, which encases numerous bacterial cells.
|
|
|
| Figure 1. Streptococcus agalactiae in chains. | Figure 2. Streptococcus agalactiae colonies in clusters; a closer look. | Figure 3. Individual colonies of Streptococcus agalactiae. |
Click to go back to:
© 2010 Dina Y. Yang. All rights reserved. **Any following links are redundant ** No photograph or the website, in whole and/or any part, may be reproduced by any means whatsoever without written permission from the photographer herself.